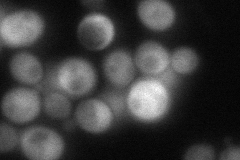
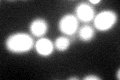

View description
Hsp70 (Ssa1p) nucleotide exchange factor, cytosolic homolog of Sil1p, which is the nucleotide exchange factor for BiP (Kar2p) in the endoplasmic reticulum
Localization:
Intensity:
Fold change:
Significance:
-
C’ GFP library in SD

cytosol95.12 -
N' NOP1pr-GFP in SD

cytosol100.302 -
N' TEF2pr-mCherry in SD

nucleus146.702 -
N' NATIVEpr-GFP in SD
cytosol90.5252 -
N' TEF2pr-VC and Cyto-VN in SD

#N/A0 -
C’ GFP library in SD+DTT
cytosol87.050.91No -
C’ GFP library in SD+H2O2

cytosol106.411.11No -
C’ GFP library in Starvation Media

cytosol123.391.29No -
C’ GFP library on the background of Pup2-DaMP

cytosol -
C’ GFP library on the background of CCT mutant

cytosol97.24931.0223No
